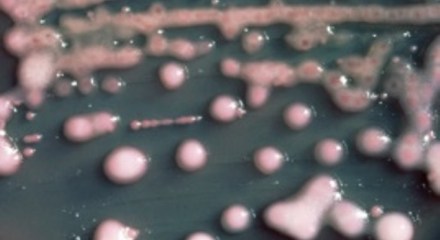

President Barack Obama : Write a letter
Hi, everyone — Yesterday, I had lunch with a woman named Rebekah at Matt’s Bar in Minneapolis. Rebekah wrote me a letter earlier this spring telling me about the challenges facing her family. More and more, she told me, she and her husband are working harder and harder just to get by. So I … Tiếp tục đọc
Ðọc sách bởi Nguyễn Hưng Quốc
Ðọc sách bởi Nguyễn Hưng Quốc Một trong những đam mê lớn nhất trong đời của tôi là đọc. Hầu như toàn bộ thời gian trong ngày của tôi, lúc nhỏ, ngoài việc học, là đọc; lớn lên, ngoài việc đi dạy để kiếm sống, và sau đó, viết lách, cũng dành cho việc đọc. Đọc, … Tiếp tục đọc
Trạm nha khoa lưu động chăm sóc răng cho trẻ em
Trạm nha khoa lưu động chăm sóc răng cho trẻ em bởi Faiza Elmasry Một bé gái được mẹ đưa đến trạm nha khoa lưu động để khám răng Khi các gia đình nghèo phải lựa chọn giữa trả tiền để gặp bác sỹ nha khoa và trả tiền để mua thức ăn, thường họ sẽ … Tiếp tục đọc
Phát hiện tính có thể lây truyền ở vi khuẩn lờn thuốc kháng sinh
Phát hiện tính có thể lây truyền ở vi khuẩn lờn thuốc kháng sinh Một dạng vi khuẩn CRE bacteria, đôi lúc được gọi là “vi khuẩn ác mông,” có thể chống lại gần như mọi loại thuốc kháng sinh, bị coi là thủ phạm gây ra 600 ca tử vong hàng năm. Các nhà … Tiếp tục đọc
Người XHCNVN Là Giòi Bọ Tại Nhật
Người XHCNVN Là Giòi Bọ Tại Nhật QLB t Công đoàn tỉnh Aichi dọa kiện đại sứ quán Việt cộng tại Nhật Sau nhiều vụ việc làm ăn bẩn thỉu, gian lận, trộm cắp của cơ quan chức quyền Việt cộng tại nhật như: – Vụ PCI (một tập đoàn chuyên cung cấp dịch vụ tư … Tiếp tục đọc
Những cây cầu lịch sử của London
Những cây cầu lịch sử của London Cập nhật: 15:30 GMT – thứ sáu, 27 tháng 6, 2014 Facebook Twitter Google+ chia sẻ Gửi cho bạn bè In trang này London có lẽ sẽ chẳng tồn tại nếu không có cây cầu nào, theo một cuộc triển lãm mới nhằm nhấn mạnh sự quan trọng của … Tiếp tục đọc
Sinh viên Hà Nội với Phong trào “Không Bán Nước”.
Sinh viên Hà Nội với Phong trào “Không Bán Nước”. CTV Danlambao – Sau hơn hai tuần lễ, tính đến nay các hoạt động ủng hộ Phong trào “Không Bán Nước” đã được tổ chức tại ít nhất 4 địa điểm trong cả nước với 6 lần thực hiện. Hoạt động mới nhất vừa được diễn … Tiếp tục đọc
Tàu cá TQ ‘chìm ở biển Hoa Đông’
Tàu cá TQ ‘chìm ở biển Hoa Đông’ Cập nhật: 11:09 GMT – thứ sáu, 27 tháng 6, 2014 Truyền thông Trung Quốc đưa tin một tàu đánh cá nước này bị chìm gần khu vực quần đảo tranh chấp giữa Trung Quốc và Nhật Bản. Năm người được cứu sống, năm người mất tích khi … Tiếp tục đọc
Hoa Kỳ, Philippines tập trận trong vùng biển tranh chấp
Hoa Kỳ, Philippines tập trận trong vùng biển tranh chấp bởi Simone Orendain Khu trục hạm USS John S. McCain trong Vịnh Subic, Philippines, 26/6/14 Tuần này, Hoa Kỳ và Philippines khởi sự các cuộc tập trận chung ở vùng Biển Ðông. Thông tín viên VOA Simone Orendain tường thuật từ Vịnh Subic rằng với một … Tiếp tục đọc